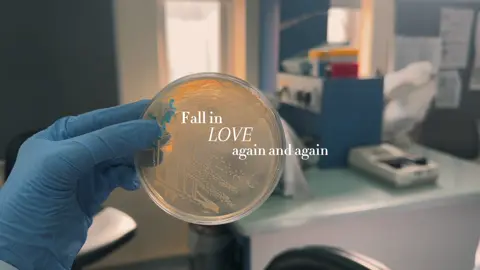

بّرق
Region: SA
Sunday 05 October 2025 10:02:49 GMT
182080
24050
93
2315
Music
Download
Comments
klb.i29 :
يعني في امل؟😓
2025-10-05 17:44:40
56
G :
ياااااااااارب تفرجها علينا
2025-10-05 21:17:09
70
شَـهـدِي🐆. :
يارب قريييب باذن الله ❤️❤️🥺😔.
2025-10-06 11:05:44
1
مشاريع ومطويات إلكترونيه 💕 :
بناتت سويت مشروع اطلبو 🥺
2025-10-05 12:53:27
26
Dr :
هذا اليقيييين الحقيقي تؤمن بقدرة ربي من وين كيف ماهو شغلك رزقك جايك جايك
2025-10-05 21:21:06
30
. :
على الله العوض
2025-10-05 22:24:03
3
M :
2025-10-05 15:00:03
14
Abdulrhman Alharbi . :
يالله يارب انك تفرجها علي وعلى كل محتاج وعلى جميع المسلمين
2025-10-06 01:34:37
3
09.03.03 :
وإني برب الظلام لست بيائس ،فالفجر من رحم الظلام سيولدُ.
2025-10-05 23:50:32
3
lara :
شكرااا
2025-10-05 20:43:04
5
لمـىَ :
ونعم بالله💕
2025-10-06 10:12:53
0
عَ :
الله كريم يامسلمين لاتيأسون من رحمته
2025-10-05 19:07:31
16
𝙺𝙷𝙰𝙻𝙴𝙳 :
ياكريم😔
2025-10-05 20:17:50
2
ꕥ Shahad ꕥ˼ ❤️ :
الحمدلله ❣
2025-10-06 05:53:27
0
A16 :
يارب
2025-10-06 00:29:26
0
piorrt80 :
ييااااارب😔
2025-10-05 20:51:24
2
️ :
يارب يجي النور بعد هالظلام
2025-10-05 21:56:07
3
R :
يارببب
2025-10-05 20:19:29
2
🐚 :
يارببب يارب
2025-10-05 22:43:43
1
عبدالعزيز🦔 :
بيجي الخير
2025-10-06 03:54:23
0
. :
2025-10-06 02:16:33
0
slo.334 :
يارب أنك تفرجها على كل مسلم ؛ ماضاقت إلا وقريب الفرج
2025-10-05 23:40:03
0
أمل📸. :
العوض باذن الله قريب 😔❣
2025-10-05 23:11:42
1
🐆 :
اي والله
2025-10-05 21:54:55
2
ghada :
يارب
2025-10-05 21:58:42
2
To see more videos from user @l1u_q, please go to the Tikwm
homepage.